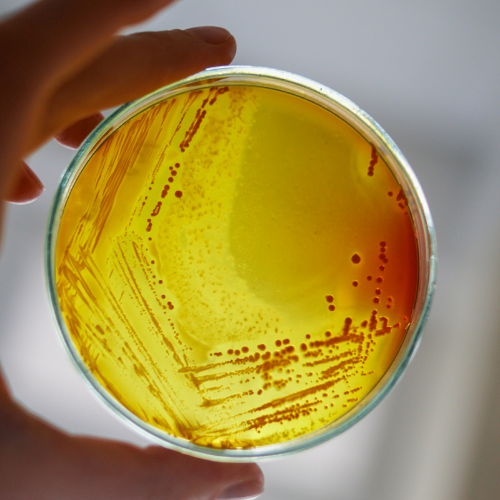

Laboratorio
ZECRONLAB
EN ZECRON trabajamos para darte un servicio integral
Desde ZECRONLAB realizamos y gestionamos distintos análisis en las aguas de proceso y consumo, ofreciendo resultados precisos y acompañamiento técnico para la correcta interpretación de los parámetros.


Análisis fisicoquímicos
Realizamos estos análisis para cualquier industria y sector:
Análisis de Legionella según normativas vigentes
Según las normativas vigentes:
Especialistas en el análisis fisicoquímico y microbiológico, proporcionamos resultados de alta precisión en aguas de proceso, consumo humano y residuales, garantizando el control de parámetros críticos como metales pesados, demandas de oxígeno y contaminantes específicos para asegurar la eficiencia operativa y ambiental de su empresa.
Análisis de aguas potables y de consumo
Análisis de aguas residuales

